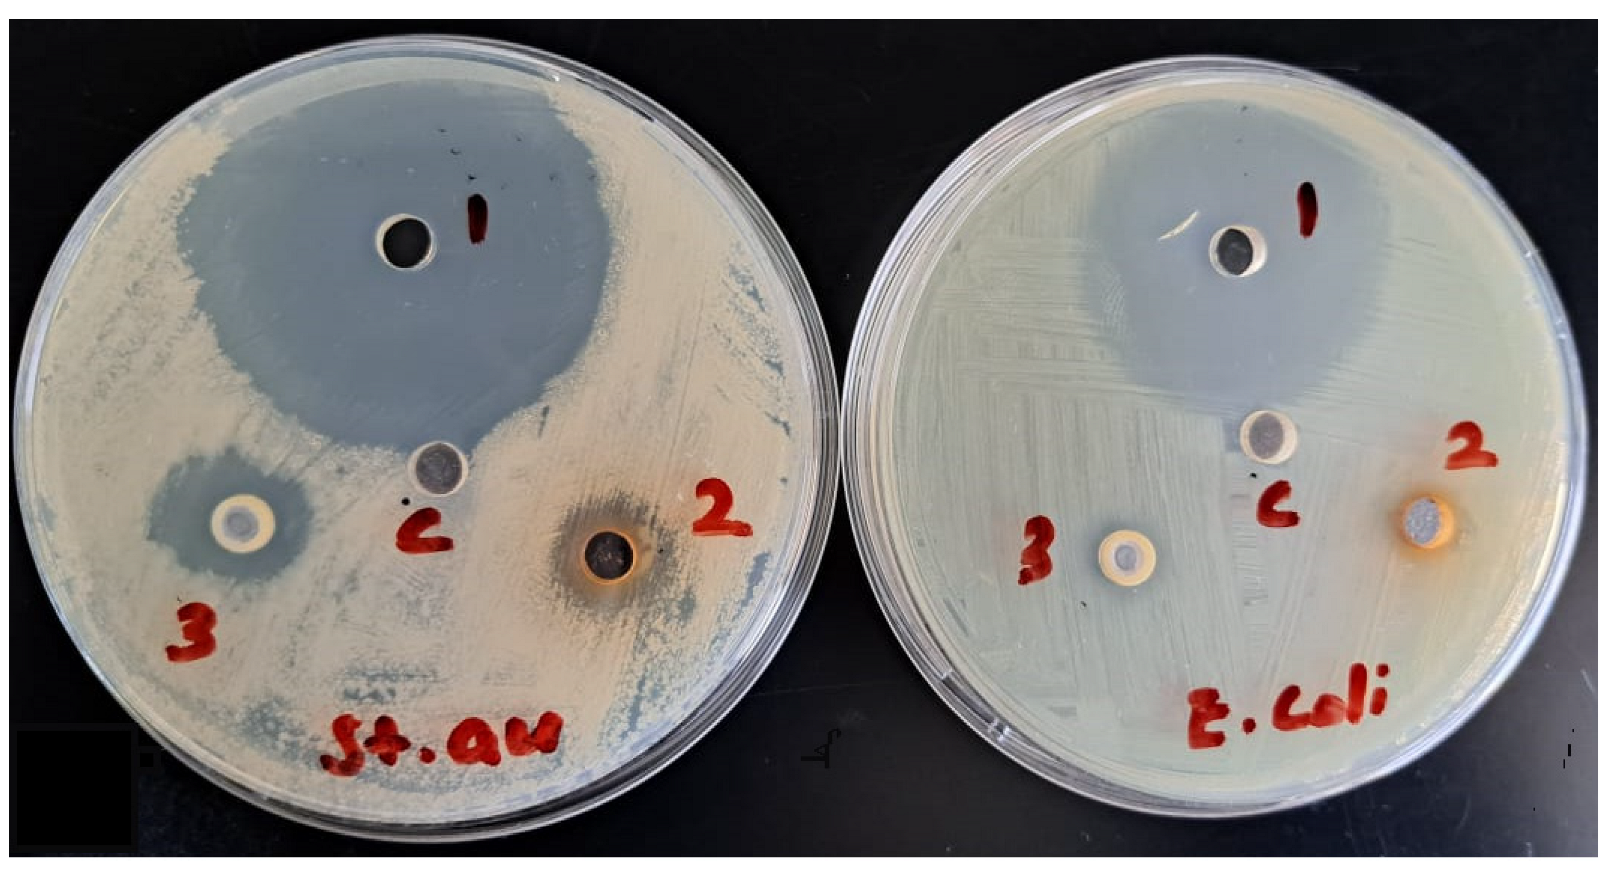

Exploring the Chemical Constituents, Antioxidant, Xanthine Oxidase and COX Inhibitory Activity of Commiphora gileadensis Commonly Grown Wild in Saudi Arabia
Abstract
1. Introduction
2. Results
2.1. Yield
2.2. Total Phenolics and Flavonoids
2.3. GC-MS Analysis
2.4. LC-MS/MS Analysis
3. Discussion
3.1. Biological Activity
3.1.1. Antioxidant Activity
3.1.2. COX-1 Inhibitory Activity
3.1.3. Xanthine Oxidase Activity
4. Materials and Methods
4.1. Collection of Plant Material and Sample Preparation
4.1.1. Ethanolic Extract of the Aerial Part of C. gileadensis
4.1.2. Extraction of Essential Oil
4.2. Phytochemical Analysis
4.2.1. Total Flavonoid Content
4.2.2. Total Phenolic Content
4.3. GC-MS Analysis
4.4. LC-MS/MS Analysis of the Extract
4.5. In Vitro Antioxidant Studies
4.5.1. DPPH (2-Diphenyl-1-Picryl-Hydrazyl) Free Radical Scavenging Activity
4.5.2. β-Carotene Bleaching (BCB) Assay
4.6. COX-1 Inhibitory Activity
4.7. Xanthine Oxidase Inhibitory Activity
4.8. Inhibition of Protein Denaturation
4.9. Antimicrobial Activity
Statistical Analysis
5. Conclusions
Supplementary Materials
Author Contributions
Funding
Institutional Review Board Statement
Informed Consent Statement
Data Availability Statement
Acknowledgments
Conflicts of Interest
Sample Availability
References
- Ushimaru, P.I.; Da Silva, M.T.N.; Di Stasi, L.C.; Barbosa, L.; Fernandes, A.A. Antibacterial activity of medicinal plant extracts. Braz. J. Microbiol. 2007, 38, 717–719. [Google Scholar] [CrossRef]
- Alsherif, E.A. Ecological studies of Commiphora genus (myrrha) in Makkah region, Saudi Arabia. Heliyon 2019, 5, e01615. [Google Scholar] [CrossRef]
- Eslamieh, J. Commiphora gileadensis. Cactus Succul. J. 2011, 83, 206–210. [Google Scholar] [CrossRef]
- Tekwu, E.M.; Pieme, A.C.; Beng, V.P. Investigations of antimicrobial activity of some Cameroonian medicinal plant extracts against bacteria and yeast with gastrointestinal relevance. J. Ethnopharmacol. 2012, 142, 265–273. [Google Scholar] [CrossRef]
- Shen, T.; Li, G.H.; Wang, X.N.; Lou, H.X. The genus Commiphora: A review of its traditional uses, phytochemistry and pharmacology. J. Ethnopharmacol. 2012, 142, 319–330. [Google Scholar] [CrossRef] [PubMed]
- Weeks, A.; Simpson, B.B. Molecular phylogenetic analysis of Commiphora (Burseraceae) yields insight on the evolution and historical biogeography of an “impossible” genus. Mol. Phylogenet. Evol. 2007, 42, 62–79. [Google Scholar] [CrossRef] [PubMed]
- Mahr, D. Commiphora: An Introduction to the Genus. Cactus Succul. J. 2012, 84, 140–154. [Google Scholar] [CrossRef]
- Barnett, J.R.; Langenheim, J.H. Plant resins: Chemistry, evolution, ecology and ethnobotany. Ann. Bot. 2004, 93, 784–785. [Google Scholar] [CrossRef]
- Abdul-Ghani, A.-S.; Amin, R. Effect of aqueous extract of Commiphora opobalsamum on blood pressure and heart rate in rats. J. Ethnopharmacol. 1997, 57, 219–222. [Google Scholar] [CrossRef] [PubMed]
- Fiorito, S.; Epifano, F.; Taddeo, V.A.; Genovese, S. Oxyprenylated ferulic acid derivatives in Italian citrus liqueurs. Czech J. Food Sci. 2016, 33, 237–241. [Google Scholar] [CrossRef]
- Al Zoubi, M.O. Evaluation of anti-microbial activity of ex vitro and callus extracts from Commiphora gileadensis. Pak. J. Biol. Sci. 2019, 22, 73–82. [Google Scholar] [CrossRef]
- Abbas, F.A.; Al-Massarany, S.M.; Khan, S.; Al-Howiriny, T.A.; Mossa, J.S.; Abourashed, E.A. Phytochemical and biological studies on Saudi Commiphora opobalsamum L. Nat. Prod. Res. 2007, 21, 383–391. [Google Scholar] [CrossRef] [PubMed]
- Iluz, D.; Hoffman, M.; Gilboa-Garber, N.; Amar, Z. Medicinal properties of Commiphora gileadensis. Afr. J. Pharm. Pharmacol. 2010, 4, 516–520. [Google Scholar]
- Newton, S.M.; Lau, C.; Gurcha, S.S.; Besra, G.S.; Wright, C.W. The evaluation of forty-three plant species for in vitro antimycobacterial activities; isolation of active constituents from Psoralea corylifolia and Sanguinaria canadensis. J. Ethnopharmacol. 2002, 79, 57–67. [Google Scholar] [CrossRef] [PubMed]
- Halub, B.; Shakya, A.; Elagbar, Z.; Naik, R. GC-MS analysis and biological activity of essential oil of fruits, needles and bark of Pinus pinea grown wildly in Jordan. Acta Pol. Pharm. Drug Res. 2019, 76, 825–831. [Google Scholar] [CrossRef]
- Dudai, N.; Shachter, A.; Satyal, P.; Setzer, W.N. Chemical composition and monoterpenoid enantiomeric distribution of the essential oils from Apharsemon (Commiphora gileadensis). Medicines 2017, 4, 66. [Google Scholar] [CrossRef] [PubMed]
- Amiel, E.; Ofir, R.; Dudai, N.; Soloway, E.; Rabinsky, T.; Rachmilevitch, S. β-Caryophyllene, a compound isolated from the biblical balm of Gilead (Commiphora gileadensis), Is a selective apoptosis inducer for tumor cell lines. Evid. Based Complement. Altern. Med. 2012, 2012, 872394. [Google Scholar] [CrossRef]
- Halliwell, B.; Gutteridge, J.M.C. Free Radicals in Biology and Medicine; Oxford University Press: Oxford, UK, 2015. [Google Scholar]
- Evans, P.J.; Whiteman, M.; Tredger, J.M.; Halliwell, B. Antioxidant properties of S-adenosyl-L-methionine: A proposed addition to organ storage fluids. Free Radic. Biol. Med. 1997, 23, 1002–1008. [Google Scholar] [CrossRef]
- Frémont, L. Biological effects of resveratrol. Life Sci. 2000, 66, 663–673. [Google Scholar] [CrossRef]
- Percival, M. Antioxidants. Clin. Nutr. Insights 1998, 1, 96. [Google Scholar]
- Patiño, L.O.J.; Prieto, R.J.A.l.; Cuca, S.L.E. Zanthoxylum genus as potential source of bioactive compounds. In Bioactive Compounds in Phytomedicine; IntechOpen: London, UK, 2012. [Google Scholar]
- El Rabey, H.A.; Al-Sieni, A.I.; Al-Seeni, M.N.; Alsieni, M.A.; Alalawy, A.I.; Almutairi, F.M. The antioxidant and antidiabetic activity of the Arabian balsam tree “Commiphora gileadensis” in hyperlipidaemic male rats. J. Taibah Univ. Sci. 2020, 14, 831–841. [Google Scholar] [CrossRef]
- Vane, J.R. Inhibition of prostaglandin synthesis as a mechanism of action for aspirin-like drugs. Nat. New Biol. 1971, 231, 232–235. [Google Scholar] [CrossRef] [PubMed]
- Mizushima, Y.; Kobayashi, M. Interaction of anti-inflammatory drugs with serum proteins, especially with some biologically active proteins. J. Pharm. Pharmacol. 1968, 20, 169–173. [Google Scholar] [CrossRef] [PubMed]
- Ben-Yehoshua, S.; Borowitz, C.; Hanus, L. Frankincense, Myrrh, and Balm of Gilead: Ancient Spices of Southern Arabia and Judea. Hortic. Rev. 2012, 39, 1–76. [Google Scholar] [CrossRef]
- Werns, S.W.; Lucchesi, B.R. Free radicals and ischemic tissue injury. Trends Pharmacol. Sci. 1990, 11, 161–166. [Google Scholar] [CrossRef]
- Cotelle, N.; Bernier, J.L.; Catteau, J.P.; Pommery, J.; Wallet, J.C.; Gaydou, E.M. Antioxidant properties of hydroxy-flavones. Free Radic. Biol. Med. 1996, 20, 35–43. [Google Scholar] [CrossRef]
- Van Hoorn, D.E.; Boelens, P.G.; Middelaar-Voskuilen, M.C.; Nijveldt, R.J.; Prins, H.; Bouritius, H.; Hofman, Z.; M’rabet, L.; van Leeuwsen, P.A.M.; van Norren, K. Preoperative feeding preserves heart function and decreases oxidative injury in rats. Nutrition 2005, 21, 859–866. [Google Scholar] [CrossRef]
- Nile, S.H.; Park, S.W. Total phenolics, antioxidant and xanthine oxidase inhibitory activity of three colored onions (Allium cepa L.). Front. Life Sci. 2013, 7, 224–228. [Google Scholar] [CrossRef]
- Wang, S.H.; Chen, C.S.; Huang, S.H.; Yu, S.H.; Lai, Z.Y.; Huang, S.T.; Lin, C.M. Hydrophilic ester-bearing chlorogenic acid binds to a novel domain to inhibit xanthine oxidase. Planta Med. 2009, 75, 1237–1240. [Google Scholar] [CrossRef]
- Al-Jaber, H.I.; Shakya, A.K.; Elagbar, Z.A. HPLC profiling of selected phenolic acids and flavonoids in Salvia eigii, Salvia hierosolymitana and Salvia viridis growing wild in Jordan and their in vitro antioxidant activity. PeerJ 2020, 8, e9769. [Google Scholar] [CrossRef]
- Tulini, F.L.; Souza, V.B.; Thomazini, M.; Silva, M.P.; Massarioli, A.P.; Alencar, S.M.; Pallone, E.M.; Genovese, M.I.; Favaro-Trindade, C.S. Evaluation of the release profile, stability and antioxidant activity of a proanthocyanidin-rich cinnamon (Cinnamomum zeylanicum) extract co-encapsulated with α-tocopherol by spray chilling. Food Res. Int. 2017, 95, 117–124. [Google Scholar] [CrossRef]
- Khalaf, N.A.; Shakya, A.K.; Al-Othman, A.; El-Agbar, Z.; Farah, H. Antioxidant activity of some common plants. Turk. J. Biol. 2008, 32, 51–55. [Google Scholar]
- Mohan, M.; Hussain, M.A.; Khan, F.A.; Anindya, R. Symmetrical and un-symmetrical curcumin analogues as selective COX-1 and COX-2 inhibitor. Eur J Pharm Sci 2021, 160, 105743. [Google Scholar] [CrossRef] [PubMed]
- Arimboor, R.; Rangan, M.; Aravind, S.G.; Arumughan, C. Tetrahydroamentoflavone (THA) from Semecarpus anacardium as a potent inhibitor of xanthine oxidase. J. Ethnopharmacol. 2011, 133, 1117–1120. [Google Scholar] [CrossRef] [PubMed]
- Kar, B.; Kumar, R.S.; Karmakar, I.; Dola, N.; Bala, A.; Mazumder, U.K.; Hadar, P.K. Antioxidant and in vitro anti-inflammatory activities of Mimusops elengi leaves. Asian Pac. J. Trop. Biomed. 2012, 2, 5–7. [Google Scholar] [CrossRef]
- Naik, R.R.; Shakya, A.K.; Ferri, B.; Oriquat, G.A.; Pistelli, L.; Numan, N.A. Volatile composition and biological activity of Jordanian commercial samples of R. coriaria L. fruits. Molecules 2021, 26, 5691. [Google Scholar] [CrossRef]

| No. | Class | CAS Registry Number | Name | Area % | Ret. Index |
|---|---|---|---|---|---|
| 1 | mh | 2867-05-2 | α-Thujene | 0.15 | 929 |
| 2 | nt | 18829-55-5 | (E)-2-Hepten-1-al | 0.02 | 958 |
| 3 | mh | 555-10-2 | β-phellandrene | 0.60 | 976 |
| 4 | nt | 110-93-0 | 6-Methyl-5-hepten-2-one | 0.07 | 984 |
| 5 | mh | 123-35-3 | β-Myrcene | 0.02 | 991 |
| 6 | nt | 123-66-0 | Ethyl caproate | 0.01 | 999 |
| 7 | mh | 99-86-5 | α-Terpinene | 0.09 | 1020 |
| 8 | mh | 527-84-4 | o-Cymene | 0.61 | 1027 |
| 9 | om | 470-82-6 | Eucalyptol | 0.44 | 1035 |
| 10 | mh | 99-85-4 | γ-Terpinene | 0.45 | 1060 |
| 11 | om | 138-87-4 | β-Terpineol | 0.54 | 1073 |
| 12 | om | 1365-19-1 | Linalool oxide | 0.25 | 1101 |
| 13 | om | 546-79-2 | 4-Thujanol | 0.77 | 1104 |
| 14 | nt | 60-12-8 | Phenylethyl alcohol | 0.23 | 1114 |
| 15 | om | 471-15-8 | β-Thujone | 0.04 | 1021 |
| 16 | om | 546-79-2 | 4-Thujanol | 0.81 | 1131 |
| 17 | om | 432-25-7 | β-Cyclocitral | 0.01 | 1130 |
| 18 | om | 471-16-9 | Cis-Sabinol | 0.02 | 1142 |
| 19 | om | 1674-08-4 | trans-Pinocarveol | 0.10 | 1145 |
| 20 | om | 1845-30-3 | cis-Verbenol | 0.06 | 1148 |
| 21 | om | 74410-10-9 | Anethofuran | 0.04 | 1152 |
| 22 | om | 17699-16-0 | trans-4-Thujanol | 0.81 | 1161 |
| 23 | om | 30460-92-5 | Pinocarvone | 0.06 | 1166 |
| 24 | nt | 7786-44-9 | 2,6-Nonadien-1-ol | 0.08 | 1172 |
| 25 | om | 33522-69-9 | trans-Verbenyl acetate | 0.32 | 1179 |
| 26 | mh | 562-74-3 | Terpinen-4-ol | 0.94 | 1185 |
| 27 | nt | 1197-01-9 | p-Cymen-8-ol | 0.19 | 1189 |
| 28 | nt | 106-32-1 | Ethyl octanoate | 0.09 | 1195 |
| 29 | om | 32543-51-4 | cis-Limonene oxide | 0.41 | 1200 |
| 30 | nt | 112-31-2 | Decanal | 0.05 | 1206 |
| 31 | om | 18881-04-4 | cis-Verbenone | 0.08 | 1212 |
| 32 | nt | 10519-33-2 | 3-Decen-2-one | 0.05 | 1215 |
| 33 | om | 1197-06-4 | cis-Carveol | 0.04 | 1221 |
| 34 | nt | 101-97-3 | Benzeneacetic acid, ethyl ester | 0.02 | 1243 |
| 35 | om | 122-03-2 | p-Cumic aldehyde | 0.06 | 1246 |
| 36 | om | 115-95-7 | Linalyl acetate | 0.12 | 1249 |
| 37 | om | 20777-49-5 | Dihydrocarvyl acetate | 0.14 | 1252 |
| 38 | nt | 3913-81-3 | 2(E)-Decenal | 0.05 | 1263 |
| 39 | om | 13040-03-4 | cis-Verbenol | 0.05 | 1282 |
| 40 | om | 76-49-3 | Bornyl acetate | 0.18 | 1287 |
| 41 | om | 73366-12-8 | (+)-cis-Verbenol, acetate | 0.03 | 1290 |
| 42 | nt | 123-29-5 | Nonanoic acid, ethyl ester | 0.17 | 1294 |
| 43 | om | 1619-26-7 | trans-ascaridol | 0.14 | 1308 |
| 44 | sh | 20307-84-0 | δ-Elemene | 0.94 | 1339 |
| 45 | sh | 17699-14-8 | α-Cubebene | 3.30 | 1353 |
| 46 | sh | 14912-44-8 | Ylangene | 1.15 | 1376 |
| 47 | sh | 3856-25-5 | Copaene | 11.48 | 1389 |
| 48 | sh | 33880-83-0 | (Z)-β-Elemene | 3.58 | 1399 |
| 49 | sh | 6813-05-4 | Sativene | 0.23 | 1407 |
| 50 | sh | 67650-50-4 | Gurjunene | 0.91 | 1411 |
| 51 | sh | 87-44-5 | Caryophyllene | 0.53 | 1429 |
| 52 | nt | 581-42-0 | 2,6-Dimethylnaphthalene | 0.09 | 1431 |
| 53 | sh | 11028-42-5 | Cedrene | 0.27 | 1435 |
| 54 | sh | 120021-96-7 | δ-muurolene | 1.09 | 1438 |
| 55 | sh | 3650-28-0 | 1,4-Methanoindan | 1.03 | 1444 |
| 56 | sh | 489-39-4 | Aromandendrene | 1.25 | 1447 |
| 57 | sh | 23986-74-5 | Germacrene D | 0.41 | 1452 |
| 58 | sh | 95910-36-4 | isoledene | 0.29 | 1456 |
| 59 | sh | 20085-19-2 | Amorphene | 0.19 | 1458 |
| 60 | sh | 6753-98-6 | Humulene | 0.39 | 1464 |
| 61 | sh | 30021-74-0 | γ-Muurolene | 0.97 | 1468 |
| 62 | nt | 18435-22-8 | 3-methyltetradecane | 0.06 | 1473 |
| 63 | sh | 18431-82-8 | Chamigren | 0.12 | 1491 |
| 64 | nt | 13360-61-7 | 1-Pentadecene | 0.87 | 1496 |
| 65 | sh | 17066-67-0 | β-Selinene | 5.02 | 1501 |
| 66 | sh | 10208-80-7 | α -Muurolene | 9.01 | 1508 |
| 67 | sh | 30021-74-0 | γ-Muurolene | 2.32 | 1522 |
| 68 | sh | 29837-12-5 | Cubenene | 3.48 | 1527 |
| 69 | sh | 73209-42-4 | trans-Calamenene | 2.65 | 1532 |
| 70 | os | 77-53-2 | Cedrol | 3.40 | 1555 |
| 71 | sh | 5937-11-1 | τ-Cadinol | 3.61 | 1568 |
| 72 | sh | 21391-99-1 | α-Calacorene | 0.44 | 1571 |
| 73 | os | 28231-03-0 | cedr-8(15)-en-9-α-ol | 0.43 | 1574 |
| 74 | nt | 6789-88-4 | Benzoic acid, hexyl ester | 0.46 | 1583 |
| 75 | os | 6750-60-3 | (+)-spathulenol | 1.28 | 1587 |
| 76 | os | 515-69-5 | α-Bisabolol | 1.47 | 1593 |
| 77 | sh | 28908-27-2 | β-Vetispirene | 0.12 | 1597 |
| 78 | os | 489-41-8 | Globulol | 2.46 | 1606 |
| 79 | os | 577-27-5 | Ledol | 0.34 | 1615 |
| 80 | os | 1139-30-6 | Caryophyllene oxide | 0.13 | 1620 |
| 81 | os | 28231-03-0 | Cedrenol | 0.80 | 1634 |
| 82 | os | 19912-62-0 | τ-Muurolol | 0.79 | 1636 |
| 83 | sh | 5937-11-1 | τ-Cadinol | 0.54 | 1651 |
| 84 | os | 28387-62-4 | α-Cedr-8(15)-en-9-al | 0.45 | 1655 |
| 85 | os | 88728-58-9 | Epiglobulol | 0.61 | 1676 |
| 86 | sh | 483-78-3 | Cadalene | 1.27 | 1681 |
| 87 | os | 77171-55-2 | (-)-Spathulenol | 0.04 | 1703 |
| 88 | nt | 544-63-8 | Tetradecanoic acid | 0.03 | 1754 |
| 89 | os | 502-69-2 | Hexahydrofarnesyl acetone | 0.01 | 1839 |
| 90 | dh | 64363-64-0 | Cembrene C | 0.03 | 1932 |
| 91 | nt | 57-10-3 | n-Hexadecanoic acid | 0.09 | 1955 |
| 92 | dh | 71213-92-8 | 3-(Z)-Cembrene A | 0.01 | 1974 |
| 93 | dh | 70000-19-0 | Verticiol | 0.01 | 2027 |
| 94 | od | 25269-17-4 | Thunbergol | tr | 2241 |
| 95 | nt | 117-81-7 | Bis(2-ethylhexyl) phthalate | tr | 2527 |
| 96 | th | 7683-64-9 | Supraene | tr | 2808 |
| monoterpene hydrocarbons (mh) | 2.86 | ||||
| oxygenated monoterpenes (om) | 5.52 | ||||
| sesquiterpenes hydrocarbons (sh) | 56.77 | ||||
| oxygenated sesquiterpenes (os) | 12.21 | ||||
| diterpene (dh) | 0.05 | ||||
| non-terpenes (nt) | 2.64 | ||||
| oxygenated diterpenes (od) | tr | ||||
| tetraterpene (th) | tr | ||||
| Total identified | 80.05 |
| No. | Class | CAS Registry Number | Name | Area % | Ret. Index |
|---|---|---|---|---|---|
| 1 | nt | 505-57-7 | 2-Hexenal | 0.05 | 850 |
| 2 | nt | 111-84-2 | Nonane | 10.88 | 900 |
| 3 | unknown | - | unknown | 0.01 | - |
| 4 | mh | 80-56-8 | α-Pinene | 2.51 | 939 |
| 5 | mh | 79-92-5 | Camphene | 0.02 | 960 |
| 6 | mh | 555-10-2 | β-Phellandrene | 9.59 | 976 |
| 7 | mh | 18172-67-3 | β-Pinene | 0.22 | 980 |
| 8 | mh | 123-35-3 | β-Myrcene | 17.44 | 992 |
| 9 | nt | 4057-42-5 | 2,6-dimethyl-oct-2-ene | 0.01 | - |
| 10 | mh | 99-83-2 | α-Phellandrene | 0.16 | 1007 |
| 11 | mh | 13466-78-9 | 3-Carene | 0.02 | 1012 |
| 12 | mh | 99-86-5 | α-Terpinene | 1.01 | 1020 |
| 13 | mh | 535-77-3 | m-Cymene | 0.39 | 1042 |
| 14 | mh | 5989-27-5 | D-Limonene | 0.43 | 1031 |
| 15 | mh | 499-97-8 | Pseudo limonene | 0.73 | 1033 |
| 16 | mh | 3779-61-1 | trans-β-Ocimene | 1.68 | 1041 |
| 17 | mh | 3779-61-1 | trans-β-Ocimene | 0.29 | 1046 |
| 18 | mh | 99-85-4 | γ-Terpinene | 1.79 | 1060 |
| 19 | nt | 4485-09-0 | 4-Nonanone | 0.05 | 1030 |
| 20 | mh | 586-62-9 | α-Terpinolene | 0.66 | 1063 |
| 21 | unknown | unknown | 0.05 | - | |
| 22 | om | 78-70-6 | Linalool | 0.52 | 1080 |
| 23 | om | 29803-82-5 | cis-p-Mentha-2-en-1-ol | 0.20 | 1123 |
| 24 | unknown | - | unknown | 0.11 | - |
| 25 | om | 562-74-3 | Terpinen-4-ol | 3.55 | 1185 |
| 26 | om | 98-55-5 | α-Terpineol | 0.25 | 1190 |
| 27 | nt | 112-31-2 | Decanal | 0.31 | 1206 |
| 28 | nt | 53398-85-9 | cis-3-Hexenyl-α-methylbutyrate | 0.06 | 1235 |
| 29 | sh | 20307-84-0 | δ-Elemene | 0.05 | 1339 |
| 30 | sh | 17699-14-8 | α-Cubebene | 0.08 | 1353 |
| 31 | Unknown | - | unknown | 0.02 | - |
| 32 | Unknown | - | unknown | 0.90 | - |
| 33 | sh | 5208-59-3 | (-)-β-Bourbonene | 0.06 | 1382 |
| 34 | sh | 30021-74-0 | γ-Muurolene | 0.84 | 1477 |
| 35 | sh | 489-40-7 | α-Gurgujene | 0.09 | 1408 |
| 36 | sh | 87-44-5 | Caryophyllene | 0.24 | 1429 |
| 37 | sh | 3691-12-1 | α-Guaiene | 0.49 | 1439 |
| 38 | Unknown | - | unknown | 0.02 | - |
| 39 | sh | 3691-11-0 | Guaia-1(10),11-diene | 0.08 | 1505 |
| 40 | Unknown | - | unknown | 0.1 | - |
| 41 | sh | 25246-27-9 | Alloaromadendrene | 0.05 | 1465 |
| 42 | sh | 523-47-7 | β-Cadinene | 0.17 | 1519 |
| 43 | sh | 483-75-0 | 7-epi-α-Cadinene | 0.03 | 1490 |
| 44 | sh | 18252-44-3 | cis-β-Copaene | 2.47 | 1433 |
| 45 | sh | 150320-52-8 | 2-isopropyl-5-methyl-9-methylene- bicyclo[4.4.0]dec-1-ene | 0.23 | 1503 |
| 46 | sh | 483-75-0 | 7-epi-α-Cadinene | 0.99 | 1495 |
| 47 | sh | 483-76-1 | δ-Cadinene | 0.08 | 1541 |
| 48 | sh | 515-13-9 | levo-β-Elemene | 0.04 | 1394 |
| 49 | sh | 39029-41-9 | γ-Cadinene | 0.11 | 1512 |
| 50 | sh | 523-47-7 | β-Cadinene | 3.64 | 1518 |
| 51 | sh | 73209-42-4 | trans-Calamenene | 1.35 | 1532 |
| 52 | sh | 16728-99-7 | Cada-1,4-diene | 0.12 | 1532 |
| 53 | sh | 24406-05-1 | α-Cadinene | 0.03 | 1538 |
| 54 | sh | 21391-99-1 | α-Calacorene | 0.34 | 1548 |
| 55 | sh | 29873-99-2 | γ-Elemene | 0.16 | 1434 |
| 56 | nt | 25152-85-6 | 3-Hexen-1-ol, benzoate, (Z)- | 0.41 | 1570 |
| 57 | os | 198991-79-6 | Germacrene -D-4ol | 0.30 | 1574 |
| 58 | os | 515-69-5 | α-Bisabolol | 0.18 | 1682 |
| 59 | os | 5937-11-1 | τ-cadinol | 1.60 | 1640 |
| 60 | os | 88728-58-9 | Epiglobulol | 1.43 | 1585 |
| 61 | os | 5986-49-2 | Palustrol | 0.03 | 1550 |
| 62 | os | 1139-30-6 | Caryophyllene oxide | 0.03 | 1589 |
| 63 | os | 198991-79-6 | D-Germacren-4-ol | 0.06 | 1569 |
| 64 | os | 481-34-5 | α-Cadinol | 0.82 | 1639 |
| 65 | os | 1209-71-8 | γ-Eudesmol | 0.03 | 1597 |
| 66 | Unknown | - | unknown | 0.02 | - |
| 67 | Unknown | - | unknown | 1.66 | - |
| 68 | os | 473-15-4 | β-Eudesmol | 2.71 | 1645 |
| 69 | os | 473-04-1 | Eudesm-7(11)-en-4-ol | 0.14 | 1689 |
| 70 | sh | 483-78-3 | cadalene | 0.08 | 1681 |
| 71 | Unknown | - | unknown | 0.03 | - |
| 72 | Unknown | - | unknown | 0.04 | - |
| 73 | Unknown | - | unknown | 0.24 | - |
| 74 | Unknown | - | unknown | 1.34 | - |
| 75 | nt | 2765-11-9 | Pentadecanal | 0.35 | 1707 |
| 76 | Unknown | - | unknown | 0.23 | - |
| 77 | Unknown | - | unknown | 0.45 | - |
| 78 | Unknown | - | unknown | 0.28 | - |
| 79 | sh | 10579-93-8 | 4,11,11-trimethyl-8-methylene-bicyclo[7.2.0]undec-4-ene | 0.04 | - |
| 80 | nt | 506-43-4 | (9Z,12Z)-octadeca-9,12-dien-1-ol | 0.02 | 2052 |
| 81 | nt | 506-44-5 | Linolenic alcohol | 0.83 | 2058 |
| 82 | Unknown | - | unknown | 0.05 | - |
| 83 | nt | 57-10-3 | n-Hexadecanoic acid | 0.21 | 1955 |
| 84 | Unknown | - | unknown | 0.36 | - |
| 85 | Unknown | - | unknown | 0.35 | - |
| 86 | sh | 495-61-4 | β-Bisabolene | 0.65 | 1509 |
| 87 | dh | 1898-13-1 | Cembrene | 1.52 | 1947 |
| 88 | mh | 500-00-5 | p-Menth-3-ene | 0.06 | 1324 |
| 89 | od | 70000-19-0 | Verticillol | 2.26 | 2037 |
| 90 | od | 25269-17-4 | Thunbergol | 0.18 | 2055 |
| 91 | Unknown | - | unknown | 0.07 | 1573 |
| 92 | Unknown | - | unknown | 0.51 | - |
| 93 | od | 150-86-7 | phytol | 0.07 | 2105 |
| 94 | Unknown | - | unknown | 0.17 | - |
| 95 | Unknown | - | unknown | 0.08 | - |
| 96 | Unknown | - | unknown | 0.79 | - |
| 97 | Unknown | - | unknown | 0.04 | - |
| 98 | Unknown | - | unknown | 0.09 | - |
| 99 | Unknown | - | unknown | 0.06 | - |
| 100 | Unknown | - | unknown | 0.04 | - |
| 101 | dh | 1898-13-1 | Thunbergen | 1.54 | 1948 |
| 102 | dh | 70000-19-0 | Verticiol | 10.56 | 2027 |
| 103 | Unknown | - | unknown | 0.63 | - |
| 104 | nt | 629-94-7 | C-21 | 0.05 | 2100 |
| 105 | Unknown | - | unknown | 0.06 | - |
| 106 | nt | 646-31-1 | tetracosane C-24 | 0.1 | 2400 |
| 107 | nt | 629-99-2 | pentacosane C-25 | 0.08 | 2500 |
| 108 | nt | 630-01-3 | c-26 | 0.09 | 2600 |
| 109 | nt | 593-49-7 | c-27 | 0.12 | 2700 |
| 110 | nt | 630-02-4 | c-28 | 0.06 | 2800 |
| 111 | nt | 630-03-5 | c-29 | 0.04 | 2900 |
| mh | monoterpene hydrocarbons (mh) | 36.9% | |||
| dh | diterpene (dh) | 14.0% | |||
| nt | non-terpenes (nt) | 13.7% | |||
| od | oxygenated diterpenes (od) | 2.5% | |||
| om | oxygenated monoterpenes (om) | 4.5% | |||
| os | oxygenated sesquiterpenes (os) | 7.3% | |||
| sh | sesquiterpenes hydrocarbons (sh) | 12.5% | |||
| unknown | 8.8% | ||||
| Total identified | 100.0% |
| Sample | Total Phenolics (mg GAE/g Extract) | Total Flavonoids (mg QE/g Extract) |
|---|---|---|
| Ethanolic extract (70%) | 18.90 ± 0.14 | 59.41 ± 1.73 |
| No. | Rt (Minutes) | Name | µg/g of Extract |
|---|---|---|---|
| 1 | 0.14 | Gallic acid | 100 |
| 2 | 3.12 | Hesperetin | 4640 |
| 3 | 3.22 | Hesperidin | 2940 |
| 4 | 4.20 | Apigenin | 61.6 |
| 5 | 4.48 | Chrysin | 1080 |
| 6 | 5.96 | Rutin | 62.5 |
| 7 | 7.01 | Caffeic acid phenethyl ester (CAPE) | 10,500 |
| 8 | 10.50 | Catechin | 385 |
| 9 | 10.53 | Caffeic acid | Tr |
| 10 | 10.59 | Myricetin | tr |
| Sample | IC50 (µg/mL) | ||||
|---|---|---|---|---|---|
| DPPH Radical Activity * | BCB | COX-1 Activity * | XO Activity * | Inhibition of Protein Denaturation | |
| Essential oil (C. gileadensis) | 22.2 ± 0.5 | - | - | - | |
| Ethanolic extract | 56.5 ± 0.4 | 75.8 ± 7.7 | 450.1 ± 8.2 | 251.2 ± 5.6 | 110.5 ± 5.8 |
| Ascorbic Acid | 1.25 ± 0.05 | - | - | - | - |
| Rutin | - | 4.5 ± 0.35 | - | - | - |
| SC560 | - | - | 0.0051 ± 0.0001 | - | - |
| Allopurinol | - | - | - | 0.41 ± 0.05 | - |
| Diclofenac Potassium | - | - | - | - | 52.2 ± 6.5 |
| Sample Name | Inhibition Zone (mm) | |
|---|---|---|
| E. coli | S. aureus | |
| Essential oil (50% emulsion in 5% DMSO, spot 3) | 10 | 20 |
| Ethanolic extract (100 µg/mL 5% DMSO, spot 2) | 9 | 15 |
| Moxifloxacin (25 µg/mL, spot 1) | 40 | 45 |
Disclaimer/Publisher’s Note: The statements, opinions and data contained in all publications are solely those of the individual author(s) and contributor(s) and not of MDPI and/or the editor(s). MDPI and/or the editor(s) disclaim responsibility for any injury to people or property resulting from any ideas, methods, instructions or products referred to in the content. |
© 2023 by the authors. Licensee MDPI, Basel, Switzerland. This article is an open access article distributed under the terms and conditions of the Creative Commons Attribution (CC BY) license (https://creativecommons.org/licenses/by/4.0/).
Share and Cite
Shadid, K.A.; Shakya, A.K.; Naik, R.R.; Al-Qaisi, T.S.; Oriquat, G.A.; Atoom, A.M.; Farah, H.S. Exploring the Chemical Constituents, Antioxidant, Xanthine Oxidase and COX Inhibitory Activity of Commiphora gileadensis Commonly Grown Wild in Saudi Arabia. Molecules 2023, 28, 2321. https://doi.org/10.3390/molecules28052321
Shadid KA, Shakya AK, Naik RR, Al-Qaisi TS, Oriquat GA, Atoom AM, Farah HS. Exploring the Chemical Constituents, Antioxidant, Xanthine Oxidase and COX Inhibitory Activity of Commiphora gileadensis Commonly Grown Wild in Saudi Arabia. Molecules. 2023; 28(5):2321. https://doi.org/10.3390/molecules28052321
Chicago/Turabian StyleShadid, Khalid A., Ashok K. Shakya, Rajashri R. Naik, Talal S. Al-Qaisi, Ghaleb A. Oriquat, Ali M. Atoom, and Husni S. Farah. 2023. "Exploring the Chemical Constituents, Antioxidant, Xanthine Oxidase and COX Inhibitory Activity of Commiphora gileadensis Commonly Grown Wild in Saudi Arabia" Molecules 28, no. 5: 2321. https://doi.org/10.3390/molecules28052321
APA StyleShadid, K. A., Shakya, A. K., Naik, R. R., Al-Qaisi, T. S., Oriquat, G. A., Atoom, A. M., & Farah, H. S. (2023). Exploring the Chemical Constituents, Antioxidant, Xanthine Oxidase and COX Inhibitory Activity of Commiphora gileadensis Commonly Grown Wild in Saudi Arabia. Molecules, 28(5), 2321. https://doi.org/10.3390/molecules28052321

